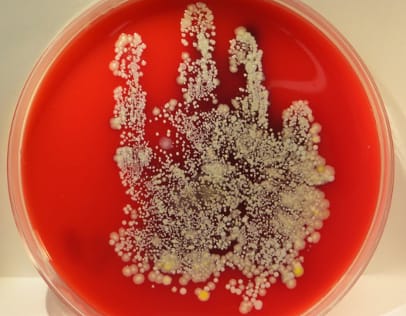
This handprint from a healthcare worker shows how much bacteria can be hiding in plain sight. (Photo courtesy of Henry Ford Health System)
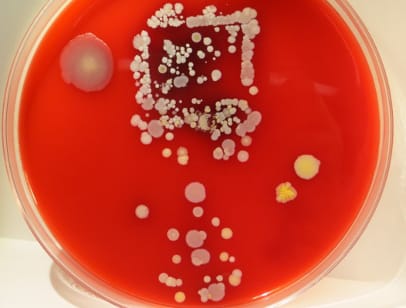
The imprint of a cell phone is clear on this growth medium, which shows how much bacteria was on the surface of a mobile phone used by unit staff at a hospital.

What could be more frightening than an unseen enemy — one so stealthy and powerful that it can send you to the hospital or even kill you? And what if that enemy is so small that you can’t see it, don’t even know that it’s there. Maybe right there on some food you’re about to eat or even on your hands?

And what if someone showed you what “the enemy” looked like by enlarging its image. And from there, showed you an enlarged photo of some of the bacteria on food or on common objects such as faucet handles, door knobs, or counter tops? Would seeing them make you want to be extremely careful about protecting yourself and others from the enemy? Would this work better than a scientist telling you their names and warning of the harm they can do. Turns out that the first option has legs, according to a handwashing study done by a Henry Ford Health System team in a Detroit hospital. The study revealed that health-care workers in the hospital increased their hand washing by at least 11 percent — in one unit by nearly 50 percent — after seeing images showing bacterial growth on items like unused gloves, doorknobs, a nurse station mouse, health-care workers’ hands, a mobile phone and an ultrasound machine. That’s especially good news because according to U.S Centers for Disease Control and Prevention, health-care providers, in general, practice hand hygiene (proper hand washing) less than half as much as they should. That’s important because proper handwashing helps reduce the spread of infections, which, in the case of food safety, would include infections from foodborne pathogens such as E. coli, Salmonella, Listeria and Campylobacter. The CDC estimates that there are more than 700,000 healthcare-associated infections in U.S. acute-car hospitals every year. In the Detroit hospital study, the team members found that showing hospital staff members images of millions of bacteria found on common surfaces was a good way to improve handwashing rates by triggering a feeling of disgust on the part of those who saw the images. As part of the study, the team developed a book of images containing bacterial cultures of different types of bacteria and different levels of contamination. Ashley Gregory, an infection prevention specialist who co-led the project, said that hospital staff wanted to wash their hands after looking at the book and picturing similar contamination on their own skin. In addition, the images also helped motivate them to clean various items such as mobile work stations and computer mouse devices in their workspaces. Looking ahead, Gregory said she is hoping that other institutions will improve handwashing compliance by using this approach. The study in the Detroit hospital was inspired by a 2014 study of handwashing in 14 Indian villages. In that study, the researchers randomly assigned 14 small villages with populations between 700 and 2,000 to either receive an emotion-driven approach to handwashing or no intervention at all.
An article in The Advisory Board, asks the question “How can you make people wash their hands?” “Gross them out,” was the answer. When the study began, handwashing rates were very low — between 1 and 2 percent — in both the intervention and control groups. Study author Val Curtis of the London School of Hygiene & Tropical Medicine, said that although handwashing with soap could prevent at least one-third of the 800,000 deaths of children under five annually from diarrhea — which is often triggered by a virus or bacteria — handwashing with soap could prevent at least one-third of these deaths. Not surprisingly, surveys reveal that handwashing is infrequent in countries such as India that don’t have running water in many areas. Curtis said that handwashing campaigns usually try to inform people with health messages about germs and diseases, but “so far these haven’t had much success when it comes to changing handwashing behavior on a large scale.” That’s why researchers from the United Kingdom and St. John’s Research Institute, along with the Bangalore communications firm, Centre of Gravity, came up with a “Super Mum” campaign, which included “emotional drivers” such as the feeling of disgust at the bacteria that can be on a person’s hands. The campaign also factored in other emotional drivers such as a mother’s desire for a happy, thriving child and the yearning on the part of mothers to fit in with what they believe others in the community are doing. The intervention group had access to an online global toolkit that targeted these emotional drivers. In addition, the group had the benefit of attending community and school-based events that included skits and animated films, along with public pledging ceremonies asking women to promise that they and their children would wash their hands at key times. An analysis of the study, which was published in The Lancet Global Health, showed these results:
- After 6 weeks, hand-washing compliance in the intervention group was 19 percent, compared with 4 percent in the control group, which received no interventions;
- After 6 months, compliance in the intervention group had risen to 37 percent, compared to 6 percent in the control group; and
- One year later, after the control group had received a shortened campaign, hand-washing in both groups was 29 percent.
Co-author of the study Katie Greenland said the campaign was effective because “it engages people at a strong emotional level, not just an intellectual level.” What about the impact on food safety? Could it be that showing people pictures of potentially deadly bacteria such as E. coli, Salmonella and Listeria on their hands, on produce, on surfaces and equipment in processing centers, and on kitchen equipment in restaurants could boost workers’ resolve to wash their hands and keep those surfaces clean? Could it also have a positive effect on farmers, farworkers, processing facility managers and owners, and restaurant owners? Co-lead of of the Detroit hospital study Ashley Gregory told Food Safety News she thinks that could be the case. “We do think people respond more to actually seeing the bacteria versus being told the name of the pathogens and warned about their harmful effects,” she said. She cited examples such as “putting a face with the monster,” which she said has proven to be a strong emotional trigger in other health campaigns. “If people still were only told about the harms of smoking versus being shown a blackened lung or a person who has to use a voice box, the amount of disgust associated with smoking probably wouldn’t be as strong.” She also said that the Detroit hospital study is particularly relevant to food safety since hand hygiene is “a vital component in the safe delivery” of foods that we eat. She cited Staphylococcus aureus, a known skin organism that can wreak havoc on a person’s digestive system, and Shigella and Salmonella, which can cause not only digestive distress but also septicemia as well, as examples. “Without proper hand hygiene, these organisms are easily transmitted to the foods we consume, and not every end consumer is diligent about washing their food and not all food will be cooked to the degree in which these bacteria can be destroyed,” she said. “Hand hygiene is crucial in keeping ourselves, our family and community healthy. Most illnesses can be prevented by performing the simple task of washing your hands, and with today’s advancement in the availability of transportable methods (alcohol gels and wipes), there is no reason not to.”
As for why some bacteria are so powerful, she said that they not only thrive but can reproduce rapidly under conditions the human body provides. “Unlike a lot of things harmful to the human body, bacteria are microscopic and therefore even large amounts of them can remain unseen to the human eye,” she said. “It only takes a small number of these bacteria to get into our body by any means — for example placing them on a peach you’re about to eat because you shook hands with someone who just defecated and didn’t wash their hands. And once they’re in your body, their only objective in life is to make your body their new home.” University of Arizona microbiologist Charles Gerba, also known as “Dr. Germ,” put it this way: “We’re their food supply,” he said. “They’re trying to find a good source of food. And it takes only 30 minutes for them to reproduce.” And once they start reproducing, as is the case when food isn’t kept at temperatures lower than 41 degrees F or higher than 140 degrees F, they move fast. Jim Mann, executive director of Handwashing for Life Institute said when people see how fast E. coli multiplies, “it scares the bejezus out of them.” “You start with one creepy little cell, and it doesn’t take long before the entire screen is filled with them,” he said. “It’s very effective. You can see people squirm. My wife can’t watch it.” He believes that visuals such as this would be a good tool in food-safety training — all the way up the ladder from the farmworkers in the fields to the people serving food in restaurants and homes. He also said that putting visual images of bacteria in portapotties out in farm fields and at work stations in restaurants might be a good idea because they would produce a reaction. “I can see the value of this,” he said. “Absolutely.” Food-safety guru, Trevor Suslow, University of California-Davis, also believes that visual images can be very effective in food-safety training. “I am a visual learner and a visual teacher, and I make every effort to use memorable images in all my trainings to create ‘messages that stick,’” he said. He also said that visualizing good and poor behavior within real-world and relatable situations is especially important when written language is a barrier, which is often the case with farmworkers and workers in agricultural processing facilities. A ‘real-life’ test case Food safety is a big deal at the Helping Hands Food Bank in Sedro-Woolley, WA. Under a nationwide program dubbed Grocery Rescue — and others like it — stores donate perishable foods that are close-dated, slightly ripe, or perhaps to plentiful to food banks. This is good food that would otherwise be sent to a landfill. The key that opens the door to these donations is food safety. The retailers and the food banks enter into contracts that require consistent, nationally recognized food-safety practices to be followed. That means that the volunteers at the food bank who pick up the groceries and bring them to the food bank have to follow strict food-safety practices, which includes covering items that need to stay chilled with a thermal blanket during transport. Once at the food bank, those foods are immediately put into the cooler. That’s important because many foods, among them lettuce and spinach, need to be kept at temperatures below 41 degrees F. to prevent any bacteria, including E. coli, that might be on them from reproducing, which most bacteria do very rapidly. Should that happen, anyone who eats the contaminated food runs the risk of becoming very ill. When several volunteers and the operations manager at Helping Hands were shown an enlarged picture of some E. coli bacteria on spinach, the reaction was immediate and dramatic. “Repulsion” would be one way to describe it. “Gross,” several of them said in unison as they backed away from the picture. “Now I’m not going to be able to eat lunch,” one of them said. Operations Manager Rebecca Schlaht said that a picture like that triggers a “natural gag reflex.” “If you can touch the nerve that produces that kind of physical reaction, you’ve got a wonderful tool,” she said. “It’s an excellent way of showing people why it’s so important to follow good food-safety practices.” Click here for CDC’s advice on how to wash your hands properly. (To sign up for a free subscription to Food Safety News, clickhere.)